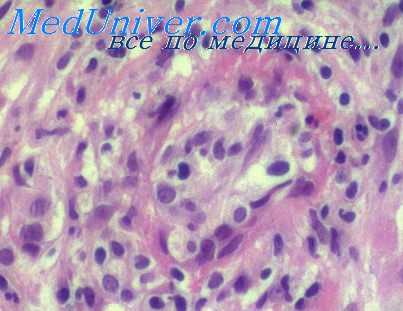
ку лихорадка

Диагностика и лечение Ку-лихорадки. Профилактика Ку-риккетсиоза
Добавил пользователь Евгений Кузнецов Обновлено: 19.12.2025
Ку-лихорадка (известна также как среднеазиатская лихорадка или легочный тиф) — острое риккетсиозное заболевание, распространенное повсеместно, и проявляющееся частым поражением ЦНС, лихорадкой и развитием специфической пневмонии.
На территории России встречается в основном на юге страны.
Эпидемиология
В природных условиях инфекция обнаруживается у многих млекопитающих, клещей, птиц. Клещи также передают болезнь трансовирально – своему потомству. Временные носители риккетсий Бернета – теплокровные животные. «Подхватывать» и переносить риккерсии могут домашние животные, которые заражаются при контакте с дикими животными и от укусов клещей. Человек заражается ку-лихорадкой, кушая зараженные продукты или при питье воды, в которой находится инфекция. Заразиться можно, кушая яйца, молоко, произведенные зараженным животным, и пр.
Следующий путь передачи инфекции – воздушно-капельный. Инфекция переносится с пылью, в которой присутствуют выделения зараженных животных. Такое происходит при обработки меха, шерсти, кожи, а также при контакте с собаками, кошками и прочими зараженными риккерсиями домашними животными.
Здоровые люди заразиться от больного не могут – этот путь передачи инфекции исключен. Основной путь заражения ку-инфекцией детей – при употреблении инфицированного молока в пищу.
Что провоцирует / Причины Ку-лихорадки у детей:
В отличие от других риккетсий, возбудитель ку-лихорадки Coxielfa burneti не имеет общих антигенов с протеем.
Патогенез (что происходит?) во время Ку-лихорадки у детей:
В патологоанатомическом отношении Ку-лихорадка представляет собой инфекционный доброкачественный ретикулоэндотелиоз без развития эндоваскулита. Под эндоваскулитом понимают воспаление внутренней поверхности кровеносного сосуда. Риккерсии в основном размножаются в клетках ретикулоэндотелиальной системы, а также (чуть меньше) — в клетках сосудистого эпителия и в макрофагах.
Самые большие изменения риккерсия вызывает в печени и селезенке, сердечно-сосудистой системе, легких.
Симптомы Ку-лихорадки у детей:
Клинические проявления очень полиморфны. От 15 до 20 суток в среднем длится инкубационный период (временной отрезок, проходящий от заражения ку-лихорадкой до проявления первых признаков). Для ку-лихорадки у детей характерно острое начало, температура тела становится высокой, чувствуется разбитость и слабость. Появляется жар, головная боль и потливость. С первых дней заболевания появляются такие симптомы:
- гиперемия слизистых оболочек миндалин
- гиперемия слизистых оболочек мягкого неба
- инъекция сосудов склер
- гиперемия лица
- одуловатость лица.
В частых случаях возникает энантема. Под энантемой у детей подразумевают сыпи на слизистых оболочках.
В пик проявления симптомов случается нередко бронхит или трахеобронхит, трахеит. Есть вероятность развития очаговой пневмонии, в более редких случаях – плевропневмонии. Течение пневмонии торпидное (вялое, без проявления явных симптомов). Почти у 100% больных детей возникают такие симптомы как неустойчивость психики, бессонница, головная боль. Высока вероятность появления галлюцинаций, болей в глазных яблоках и мышцах. Дети старшего возраста могут жаловать на то, что у них болит живот, стул жидкий. В тяжелых случаях ку-лихорадки у детей возможно развитие серозного менингита, энцефалита.
Основным симптомом рассматриваемого заболевания является длительное повышение температуры. Почти во всех случаях лихорадка постоянная или с ремиссиями. Ребенок обильно потеет, часто есть озноб. Лихорадка может длиться как несколько дней, так и 3-4 недели (также больше – в отдельных случаях).
Общее состояние больного ребенка при заболевании ку-лихорадкой удовлетворительное или среднетяжелое во время всего периода болезни. От пути инфицирования (заражения) зависит степень поражения органов и систем организма.
У части детей выражаются в основном симптомы поражения нервной системы, у других — желудочно-кишечного тракта, еще у части больных детей — поражения органов дыхания. Потому считается, что ку-лихорадка имеет множество клинических проявлений, что делает диагностику данного заболевания довольно сложным делом.
Ку-лихорадка у детей бывает таких форм:
- легкая,
- среднетяжелая,
- тяжелая.
В очагах инфекции у детей в частых случаях фиксируются субклинические и стертые формы болезни, которые можно выявить с помощью серологических методов (изучение определенных антител или антигенов в сыворотке крови больных, основанное на реакциях иммунитета).
Болезнь протекает остро (длительность до 2-3 недель), подостро (выздоровление наступает через 1,5 месяца и ранее) и хронически (длительностью до 1 года). Есть вероятность рецидивов.
Диагностика Ку-лихорадки у детей:
Подозрение на ку-лихорадку возникает на основании длительного повышения температуры с потами, мышечными болями, артралгиями, головными болями в эндемическом очаге.
Чтобы поставить окончательный диагноз, применяют лабораторные методы. Применяют РСК, РН, кожно-аллергическую пробу. Выделяют R. burneti из крови больного ребенка, спинномозговой жидкости, мочи, мокроты. Материалом от больных заражают морских свинок, белых мышей или хлопковых крыс. Риккетсии Бернетав большом количестве накапливаются в печени, селезенке и других органах зараженных животных.
Лечение Ку-лихорадки у детей:
Для лечения применяют антибиотики на основе тетрациклина и левомицетина в дозах, соответствующих возрасту. Курс лечения длится от 7 до 10 дней. Также применяют симптоматические средства.
Профилактика Ку-лихорадки у детей:
Профилактические меры заключаются в истреблении клещей в лесах и других средах их обитания, в защиту домашних животных от нападения клещей, строгом соблюдении карантина в отношении больных животных. Проводят санитарно-просветительную работу среди населения, в особенности в эндемических очагах.
Необходимо всегда тщательно соблюдать правила личной профилактики при уходе за больными домашними животными. Молоко пьют только кипяченным – кипячение уничтожает инфекцию, предотвращая заражение ку-лихорадкой детей и взрослых. Для активной иммунизации предложена живая вакцина М-44, которую вводят строго по эпидемиологическим показаниям.
К каким докторам следует обращаться если у Вас Ку-лихорадка у детей:
Вас что-то беспокоит? Вы хотите узнать более детальную информацию о Ку-лихорадки у детей, ее причинах, симптомах, методах лечения и профилактики, ходе течения болезни и соблюдении диеты после нее? Или же Вам необходим осмотр? Вы можете записаться на прием к доктору .
Пятнистая лихорадка Скалистых гор ( Американский клещевой риккетсиоз , Бразильский сыпной тиф , Горная лихорадка )
Пятнистая лихорадка Скалистых гор – это острый природно-очаговый зооноз с преимущественно трансмиссивным механизмом передачи, вызываемый риккетсиями. Клиническая картина характеризуется наличием лихорадки, общеинтоксикационного синдрома, обильной макуло-папулезной сыпи с геморрагическим компонентом, признаков поражения нервной и сердечно-сосудистой систем. Диагностика основана на обнаружении серологических маркеров в сыворотке крови пациента. Используется метод ПЦР. Лечение проводится антибактериальными препаратами из группы тетрациклинов. Параллельно назначается симптоматическая терапия.
МКБ-10
Общие сведения
Причины
Возбудитель пятнистой лихорадки – грамотрицательная палочка Rickettsia rickettsii. Отличается выраженным полиморфизмом. В клетках обнаруживается как в цитоплазме, так и в ядре. Микроорганизм чувствителен к нагреванию, быстро инактивируется при температуре свыше 50° С и под воздействием дезинфицирующих средств. Устойчив к замораживанию, долго сохраняется в высушенном состоянии. Резервуар и источник инфекции – дикие грызуны, рогатый скот, собаки. Кроме того, переносчиками и стойким резервуаром считаются иксодовые клещи определенных видов. Человек является случайным хозяином. Заражение происходит при укусе насекомого либо при раздавливании и втирании клеща в области расчесов. У переносчика риккетсии персистируют в течение всей жизни, передаются трансовариально.
Патогенез
Патогенез пятнистой лихорадки Скалистых гор связан с тропностью риккетсий к клеткам эндотелия. Первичный очаг после укуса клеща не образуется. Паразит попадает в регионарные лимфатические узлы, а затем в системный кровоток. Патоген фиксируется на клетках эндотелия, проникает в них и способствует развитию некроза. Преимущественно поражаются сосуды мелкого и среднего калибра различной локализации. Вследствие этого образуются пристеночные тромбы, усиливается продукция биологически активных веществ с увеличением степени интоксикации, начинают вырабатываться антитела к эндотелиоцитам.
Вокруг пораженных сосудов формируются инфильтраты, состоящие из лимфоцитов, макрофагов, плазмоцитов и микроскопически напоминающие гранулемы. Развиваются деструктивные или деструктивно-пролиферативные васкулиты. При вовлечении в патологический процесс мышечной стенки сосудов наблюдаются панваскулиты. Наиболее часто встречается поражение сосудов почек, надпочечников, кожи, сердца и головного мозга. Характерная сыпь является следствием патоморфологических изменений сосудов кожи. При обтурации просвета тромбом формируются некрозы соответствующих анатомических областей.
Классификация
Течение риккетсиоза может быть разнообразным и сопровождаться различными симптомами. Основная триада заболевания включает выраженную лихорадочную реакцию, головную боль и характерную сыпь, которая появляется за короткий промежуток времени. В клинической практике преобладают среднетяжелые и тяжелые формы заболевания. Американские ученые предложили следующую классификацию пятнистой лихорадки Скалистых гор:
- Амбулаторная форма. Наблюдается субфебрильная температура. Выявляется незначительная интоксикация с умеренным ощущением недомогания, слабости. Высыпания могут быть нетипичными, с нехарактерной локализацией или отсутствовать вообще.
- Абортивная форма. Отмечается резкий подъем температуры до высоких цифр. Лихорадочный период составляет около 7 дней. Специфическая сыпь также сохраняется примерно в течение недели, потом исчезает, сменяясь длительной пигментацией и шелушением.
- Типичная форма. Формируется типичная клиническая картина с выраженной лихорадкой продолжительностью около 3 недель, головными и мышечными болями. Геморрагическая сыпь вначале выявляется на конечностях, затем распространяется к центру тела.
- Молниеносная форма. Характеризуется крайне тяжелым течением с выраженной интоксикацией и декомпенсацией состояния. Больной с первых дней может впасть в кому. В большинстве случаев завершается летальным исходом через 4-5 дней.
Симптомы лихорадки
Инкубационный период может составлять до 2 недель, в среднем длится 7 дней. Иногда разгару заболевания предшествует короткий продромальный период, проявляющийся недомоганием, головными болями, потерей аппетита. Обычно заболевание начинается остро с резкого подъема температуры тела до 39-41° С, выраженных артралгий, миалгий и головных болей. Возможны боли в животе, имитирующие острый аппендицит (чаще у детей). У некоторых больных выявляются отеки дорсальной стороны ладоней. Нередко возникает тошнота, рвота, носовые кровотечения. В отдельных случаях формируется периорбитальный отек, инъекция сосудов конъюнктивы. При осмотре полости рта обнаруживаются геморрагические высыпания на слизистых оболочках. Постепенно лихорадка приобретает ремиттирующий характер с суточными колебаниями температуры до 1,5° С. Лихорадочный период продолжается 2-3 недели.
Соматическая симптоматика чаще всего включает признаки поражения сердечно-сосудистой системы и ЦНС. Возможна гипотензия, брадикардия, глухость сердечных тонов. Тахикардия соответствует крайне тяжелому течению заболевания. Нередки коллапсы. Вовлечение нервной системы сопровождается бредом, судорогами, парезами и параплегиями, параличами черепно-мозговых нервов, появлением патологических рефлексов, нарушениями сознания разной степени выраженности вплоть до развития комы. Редко выявляется гепатолиенальный синдром. Более чем у половины пациентов появляются запоры. Специфические симптомы поражения дыхательной и мочевыделительной систем отсутствуют.
Осложнения
Самыми распространенными осложнениями пятнистой лихорадки Скалистых гор являются пневмонии и флебиты. Возможно развитие гломерулонефрита, миокардита с возникновением острой сердечной недостаточности, невритов, иритов и облитерирующего эндартериита, формирование гангрены характерной локализации. При поражении черепных нервов отмечается появление соответствующей симптоматики (обычно – нарушений функций органов слуха и зрения). Иногда выявляются судороги, менингизм, синдром Гийена-Барре. Наиболее грозным осложнением считается кома. Со стороны желудочно-кишечного тракта могут наблюдаться кровотечения различной локализации, перфорации, гепатомегалия с желтухой. Отмечены случаи быстрой декомпенсации у лиц, страдающих алкоголизмом, и у чернокожих мужчин с дефицитом глюкозо-6-фосфатдегидрогеназы.
Диагностика
При физикальном осмотре врач-инфекционист обнаруживает специфическую сыпь на кожных покровах, иногда – наличие геморрагических элементов на слизистой оболочке ротовой полости. Редко наблюдается первичный аффект с регионарным лимфаденитом. При признаках поражения ЦНС назначается консультация невролога, который выявляет патологические рефлексы и симптомы поражения черепных нервов. Для диагностики пятнистой лихорадки Скалистых гор используют следующие лабораторные методы:
- Общелабораторные исследования. В общем анализе крови определяется анемия, тромбоцитопения. По результатам биохимического исследования крови возможны нарушения электролитного баланса в виде гипонатриемии, иногда – повышение уровней билирубина, печеночных трансаминаз, мочевины и креатинина. В спинномозговой жидкости отмечается лейкоцитоз с повышенным или нормальным уровнем глюкозы.
- Выявление инфекционных маркеров. Используют определение нарастания титра специфических антител в крови пациента методом ИФА, РИФ. Диагностически значимым считается титр IgM>1:64, IgG>1:128. Для выделения патогена применяют биопробу. Разработана ПЦР-диагностика. Высокой специфичностью обладает реакция связывания комплемента.
Дифференциальный диагноз проводят с другими пятнистыми лихорадками, эндемическим и эпидемическим тифом, а также лептоспирозом, иерсиниозом и вторичным сифилисом. Необходимо исключить моноцитарный эрлихиоз и гранулоцитарный анаплазмоз человека. Иногда требуется дифференцировка с геморрагическими васкулитами и инфекционной эритемой. У детей важно отличить риккетсиоз от фарингита, вызываемого стрептококком группы А, с появлением сыпи после острого периода.
Лечение пятнистой лихорадки
Лечение должно проводиться в стационаре под контролем инфекциониста с возможностью перевода в палату интенсивной терапии. Назначаются антибактериальные средства тетрациклинового ряда, возможно использование тетрациклина и доксициклина. При лечении беременных женщин препаратом выбора является хлорамфеникол. Параллельно проводится симптоматическая терапия (жаропонижающие, внутривенные инфузии). Особое внимание уделяют контролю электролитного и водного баланса. При развитии осложнений план лечения корректируется в соответствии с характером патологических изменений.
Прогноз и профилактика
Прогноз сомнительный. Летальность, по разным данным, составляет от 5 до 80%. Раннее выявление патологического состояния и своевременное назначение антибактериальных препаратов способствует благоприятному исходу заболевания. Выздоровление длительное, особенно при поражении различных систем организма, может сопровождаться формированием стойких нарушений. Специфическая профилактика не проводится. Неспецифические мероприятия включают истребление грызунов и клещей, ношение специальной защитной одежды, использование репеллентов и индивидуальных средств защиты. Большое значение имеет правильное извлечение клеща и раннее начало антимикробного лечения при появлении первых симптомов заболевания.
1. Дерматология Фицпатрика в клинической практике. Том 3 / Голдсмит Л.А., Кат С.И., Джилкрест Б.А. и др. – 2018.
Диагностика и лечение Ку-лихорадки. Профилактика Ку-риккетсиоза
Механизм развития Ку-лихорадки. Клиника Ку-риккетсиоза
Независимо от входных ворот возбудитель попадает в кровь и размножается в органах ретикулогистиоцитарной системы (в гистиоцитах и макрофагах) без развития панваскулита, как это наблюдается при других риккетсиозах.
В дальнейшем они вновь выходят в кровь и размножаются в эндотелии кровеносных сосудов, вызывая общую интоксикацию. В части случаев риккетсии длительно персистируют из-за недостаточного иммунного ответа организма, что ведет к развитию хронических форм болезни. Патологоанатомические материалы ограничены, так как прогноз болезни благоприятный.
В целом они сводятся к обнаружению интерстициальной пневмонии; в печени находят очаги повреждения гепатоцитов с отечностью и инфильтрацией эозинофилами и моноцитами; в селезенке - гиперплазия пульпы; в ЛУ - гранулемы из эпителиальных клеток; в почках - набухание канальцевого эпителия; в головном мозге - точечные геморрагии и периваскулиты без образования экссудата. Находили энцефалит и менингит; эндокардит с диссеминацией риккетсии по всем органам.
Инкубационный период от 3 до 32 дней; во время эпидемических вспышек инкубация в пределах 12-19 дней; в опыте на добровольцах и при лабораторном заражении инкубационный период колебался от 10 до 17 дней. Лихорадка Ку - острый, циклически протекающий доброкачественный инфекционный ретикулоэндотелиоз, характеризующийся полиморфизмом клинических проявлений. В течении болезни выделяют начальный период (3-5 дней), период разгара болезни (4-8 дней) и период реконвалесценции.
Болезнь начинается остро, порой внезапно, с озноба и повышения температуры; у некоторых - с появления чувства жара, сильной головной боли, разбитости и слабости, потливости, иногда до профузного пота, боли в мышцах, пояснице, иногда в суставах; может начинаться с боли в глазницах и глазных яблоках, ретробульбарной боли и носового кровотечения; появляется сухой кашель, нарушения сна вплоть до бессоницы. У некоторых больных болезнь через 3-6 дней заканчивается, за что получила в начале изучения название «летний грипп». В других, более частых случаях, заболевание прогрессирует и достигает стадии разгара, а затем длительной реконвалесценции с медленным восстановлением сил. В связи с этим выделяют следующие формы: острую (2-3 недели), которая встречается у подавляющего числа больных (75-80%), подострую (длительностью до месяца и более) у 15-20% больных, а также хроническую форму с длительностью до года и более (у 3-5%).
Клинические проявления могут быть с преимущественным поражением той или иной системы и различных органов. Выделяют следующие формы: пневмоническую, гриппоподобную, тифоподобную, бруцеллезоподобную, нервную, иногда с развитием менингоэнцефалита. Осложнения наблюдаются при всех вариантах тяжелого течения болезни (плеврит, бронхоэктазии, инфаркт легкого, панкреатит, эпидидимит, пиелонефрит, тромбофлебит, иногда в разгаре болезни у больных могут быть галлюцинации и психозы.
Летальные исходы единичны. Описаны рецидивы болезни. Повторные заболевания возможны через несколько лет, так как иммунитет непрочный и непродолжительный.
Информация на сайте подлежит консультации лечащим врачом и не заменяет очной консультации с ним.
См. подробнее в пользовательском соглашении.
При лихорадке Ку эффективны тетрациклины и левомицетин в обычных терапевтических дозах, применяемые в течение 5-7 дней (по 0,5 г 4 раза в день). Если температура при этом лечении не снижается, то через 3 дня их применения переходят на другие антибиотики (рифампицин). Возможны комбинация тетрациклина с бактримом. При тяжелых формах антибиотики вводят внутривенно. Рекомендуется сочетать этиотропную терапию с антигистаминными и противовоспалительными препаратами (бутадион, амидопирин). При отсутствии эффекта назначают глюкокортикоидные гормоны, в частности, преднизолон по 30-60 мг в сутки, дексаметазон (по 4-8 мг), триамсиналон (по 20 мг в сутки) или гидрокортизон (по 80-120 мг в сутки). Длительность гормональной терапии 5-8 дней. Проводят также дезинтоксикационную и симптоматическую терапию.

Профилактика Ку-риккетсиоза
Лихорадка Ку распространена во многих странах мира. По официальным данным, в России в разные годы регистрируется до 1,5-2 тыс. случаев заболеваний. Северные области России почти свободны от лихорадки Ку. При этом следует учесть возможность легких и стертых форм, которые не диагностируются. Человек как источник инфекции в распространении лихорадки Ку роли не играет.
Резервуаром и источником инфекции в природе являются более 90 видов мелких млекопитающих (преимущественно грызунов), около 60 видов птиц и 70 видов клещей (у клещей сохранение вируса длительное, так как возможна трансовариальная передача риккетсий). Возбудитель, кроме трансмиссивной передачи, попадает в организм человека аэрогенно (чаще всего с пылью, в которой содержатся экскременты больных животных). В антропургических очагах источником инфекции являются сельскохозяйственные домашние животные (крупный и мелкий рогатый скот), которые инфицируются от природных источников инфекции. Заражение человека происходит контактным (раздавливание клещей перед доением коров), алиментарным и трансмиссивным путями. Преобладают аэрогенный и пищевой путь заражения (через молоко и молочные продукты).
Зооветеринарные работники могут заражаться в период наступления у животных отелов, окотов, когда им приходится оказывать помощь. Околоплодные воды животных содержат практически чистую культуру риккетсий, так же как при бруцеллезе. Болеют лихорадкой Ку люди всех возрастов и обоих полов. Наибольшему риску заражения подвержены лица, связанные своей трудовой деятельностью с уходам за животными и обработкой продуктов животноводства. Заболевания возникают в любое время года, но чаще в период отелов и окотов; эпидемические вспышки лихорадки Ку связаны с завозом сельскохозяйственной продукции (шерсть, хлопок, солома и др.) из местности, неблагополучной по этому заболеванию.
Профилактика основана на социально-гигиенических и ветеринарных предупредительных мерах. Вакцинацию против лихорадки Ку проводят по эпидемическим показаниям лицам угрожаемых профессий.
- Вернуться в оглавление раздела "Микробиология."
Лихорадка Ку
Лихорадка Ку – риккетсиозная инфекция, протекающая с лихорадочным синдромом и поражением легких, в частности, с развитием атипичной пневмонии. Начальный период лихорадки Ку характеризуется общетоксическими проявлениями; в период разгара доминируют симптомы трахеита, бронхита, пневмонии. Диагноз лихорадки Ку основан на комплексе клинико-эпидемиологических и лабораторных данных (РСК, ИФА, РНФ, бактериологический анализ), внутрикожных и биологических проб, рентгенографии легких. Основу лечения лихорадки Ку составляет антибиотикотерапия; дополнительно проводится дезинтоксикационная, десенсибилизирующая, противовоспалительная терапия, ингаляции.
Лихорадка Ку (Q-лихорадка, пневмориккетсиоз, балканский грипп) – острый, природно-очаговый клещевой риккетсиоз, характеризующийся преимущественным поражением дыхательной системы. Лихорадка Ку распространена во всех географических зонах, наиболее широко в Австралии и Америке. Спорадические и групповые случаи заболевания также регистрируются в Европе, Азии, ряде районов России и СНГ. Лихорадка Ку отличается высокой контагиозностью, к инфекции восприимчивы лица различного возраста. Чаще заражаются жителей сельской местности, работающие на животноводческих фермах, птицефермах, скотобойнях; занятые охотой, сбором, хранением и переработкой мяса, кожи, меха и пуха. Несмотря на незначительный удельный вес лихорадки Ку в структуре инфекционных заболеваний, высокая частота тяжелых пневмоний и осложнений определяют актуальность и инфекционную настороженность в отношении данной патологии.
Причины лихорадки Ку
Возбудителями лихорадки Ку являются облигатные внутриклеточные паразиты - риккетсии Бернета (коксиеллы, Coxiella burnetii). Они представляют собой мелкие неподвижные грамотрицательные бактерии, способные образовывать фильтрующиеся и спорообразные формы. Риккетсии Бернета обитают и репродуцируются в живых, активно метаболизирующих клетках - внутри эпителиоцитов кишечного тракта клещей, в клетках различных органов и систем человека. Возбудителя лихорадки Ку отличает высокая устойчивость к факторам внешней среды: вне живого организма они сохраняют жизнеспособность несколько месяцев. Коксиеллы устойчивы к ультрафиолетовым лучам, дезинфектантам (хлорной извести, формалину), повышенной и низкой температуре, однако при кипячении погибают в течение одной минуты.
Природным источником возбудителя лихорадки Ку выступает более 40 разновидностей клещей (в основном, иксодовые, а также гамазовые, аргасовые и др.), инфицированные дикие и домашние животные, птицы, выделяющие коксиелл в окружающую среду на протяжении всего периода заболевания. Передача инфекции человеку осуществляется различными путями: аспирационным, алиментарным, контактным, трансмиссивным. Чаще всего возбудитель лихорадки Ку проникает через слизистые оболочки дыхательных путей при вдыхании инфицированной пыли во время обработки шкур и шерсти животных; через поврежденные кожные покровы при уходе за больными животными; через ЖКТ при употреблении инфицированных мяса, молока, воды. Природные очаги лихорадки Ку поддерживаются зараженными клещами. Инфицирование людей чаще происходит в весенне-летне-осенний период.
В месте проникновения возбудителя в организм человека воспалительной реакции не возникает. Бактериемия приводит к поражению ретикулогистиоцитарной системы, сопровождается выраженной токсемией, развитием специфических дистрофических изменений в сердечно-сосудистой и нервной системах, почках, других внутренних органах. Риккетсии Бернета обладают выраженной пневмотропностью, поэтому при лихорадке Ку наибольшие изменения возникают в дыхательной системе.
Симптомы лихорадки Ку
Лихорадка Ку может протекать в острой, подострой и хронической форме. В динамическом течении заболевания выделяют инкубационный, начальный период, период разгара и реконвалесценции. Инкубационный период варьирует от 3 до 30 дней (в среднем 19-20 дней).
Заболевание начинается внезапно, с быстрого подъема температуры до 39-40˚C, озноба и потливости, сопровождающихся сильной головной болью, миалгией и артралгией, выраженной слабостью и бессонницей. Часто наблюдается гиперемия лица и шеи, слизистой зева, инъекция сосудов склер и конъюнктивы. Иногда отмечается сыпь розеолезного или пятнисто-папулезного характера. Выявляются приглушенные тоны сердца, брадикардия, умеренная артериальная гипотензия. Начальный период лихорадки Ку продолжается 7-9 дней. Через несколько дней температура снижается, непродолжительно держится на субфебрильных значениях, пока не наступает вторая волна лихорадки.
В разгар заболевания начинают доминировать признаки поражения органов дыхания – развивается картина трахеита, бронхита или атипичной пневмонии. Больных лихорадкой Ку беспокоит чувство стеснения в груди, кашель сухой или с выделением скудной мокроты, сопровождающийся болью в грудной клетке. С развитием пневмонии кашель становится влажным с серозно-гнойной мокротой, иногда с примесью крови; появляется одышка, выслушиваются сухие, реже влажные мелкопузырчатые хрипы. Течение пневмонии при лихорадке Ку – торпидное, с медленным разрешением клинических и рентгенологических признаков.
Стадия реконвалесценции протекает с постепенным снижением температуры, улучшением самочувствия больных, исчезновением основных клинических симптомов. Отмечается длительный астенический синдром, восстановление работоспособности происходит медленно. Подострая форма лихорадки Ку имеет продолжительность от 1 до 3 месяцев, обычно легкое или среднетяжелое течение с волнообразным небольшим подъемом температуры. Для хронической формы характерен часто рецидивирующий, вялотекущий процесс длительностью от нескольких месяцев до 1 года и более.
Осложнения лихорадки Ку наблюдаются нечасто. В отдельных случаях может развиться плеврит, инфаркт легкого, эндокардит, менингоэнцефалит, пиелонефрит, панкреатит, гепатит, орхит или эпидидимит риккетсионной природы, тромбофлебит глубоких вен конечностей, неврит. Присоединение вторичной инфекции сопровождается формированием абсцессов.
Диагностика лихорадки Ку
Диагноз лихорадки Ку основывается на комплексе клинико-эпидемиологических данных, результатах лабораторного и инструментального обследования. В крови больных лихорадкой Ку отмечается тромбоцитопения, относительный лимфо- и моноцитоз, умеренное увеличение СОЭ; в моче - протеинурия и гематурия. Лихорадку Ку подтверждает выделение культуры возбудителя в крови, моче, мокроте, ликворе больных с помощью бактериологического посева на тканевые среды или методом биологической пробы на морских свинках и грызунах. Чистые культуры риккетсий получают путем введения исследуемого материала в куриные эмбрионы.
Рентгенография грудной клетки при риккетсиозной пневмонии выявляет мелкоочаговые инфильтраты в нижних отделах и прикорневых зонах, усиление легочного рисунка, уплотнение и расширение корней легких, увеличение перибронхиальных лимфоузлов. Специфическая диагностика лихорадки Ку включает серологические методы: РСК, РНФ, ИФА, внутрикожные пробы с очищенным антигеном возбудителя. Диагностические титры становятся положительными на 10-12 день заболевания и достигают максимума к 3-4 неделе.
Природные очаги лихорадки Ку определяют исследованием гемолимфы и кишечника клещей, а также препаратов-отпечатков внутренних органов животных на наличие риккетсий Бернета. Необходимо проведение дифференциальной диагностики лихорадки Ку с туберкулезом легких, гриппом, сыпным и брюшным тифом, острым и подострым бруцеллезом, лептоспирозом, туляремией, пневмониями различного генеза, сепсисом.
Лечение и профилактика лихорадки Ку
Целесообразен прием антигистаминных препаратов, НПВС, поливитаминов. По показаниям назначается дезинтоксикационная терапия; при развитии патологии дыхательной системы проводится оксигенотерапия, ингаляции с бронходилататорами. При тяжелых формах лихорадки Ку применяются кортикостероиды (преднизолон, дексаметазон).
Прогноз лихорадки Ку благоприятный, большинство случаев заболевания заканчивается полным выздоровлением, иногда могут развиваться затяжные и хронические формы заболевания. Летальные исходы наблюдаются крайне редко. Профилактика лихорадки Ку включает комплекс противоэпидемических, ветеринарных и санитарно-гигиенических мероприятий. Эти меры предполагают проведение противоклещевой обработки пастбищ, уничтожение грызунов, ветеринарный надзор за скотом, тщательную термическую обработку мяса, молока и воды. В природных очагах особую актуальность имеют вопросы соблюдения личной гигиены, иммунизации лиц группы риска живой вакциной.
Читайте также:
